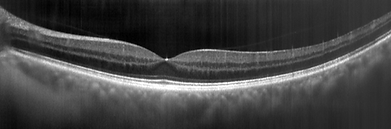
avg466_removefixedpatterns-2.png

Line-Scan Swept-Source OCT Systems
Miniaturized, massively Parallel high-performance OCT imaging.
Line-Scan OCT Architecture
At the core of every KineoLabs' OCT system is the proprietary wavelength-sweeping laser engine. KineoLabs' line-scan OCT architecture is unique in the marketplace since it acquires data line-by-line rather than point-by-point. This has major advantages:
-
Massively parallel (2k or more points in one line) acquisition
-
Much more affordable than conventional point scanning systems due to parallel data acquisition electronics
-
State-of-the-art image fidelity and optical efficiency
-
Small system footprint in a portable form factor
-
Simplicity in design with small number of components leading to low manufacturing complexity and increased ruggedness
-
Free-space optical design - no fibers and external light sources needed!
The platform supports both ophthalmic and industrial imaging use cases. It can be configured for line-field or full-field (3-D) architectures, depending on application needs.

Product concept of a hand-held OCT for ophthalmology.
Live video at 160 Hz frame rate of spatially aligned raw OCT retinal image data.
OPTHALMIC LINE-SCAN OCT APPLICATIONS
Retinal OCT
KineoLabs OCT systems are ultra-compact for portable use or mounting on the slit lamp in the exam or workup room of ophthalmic offices eliminating the need for a dedicated imaging room. This unlocks new practice workflows that improve efficiency, reduce patient movement and comfort, and increase daily patient throughput. The small size and performance also make it ideal for integration into equipment for surgical procedures.
No Compromise Clinical-Grade Performance
Our swept-source OCT system enables:
-
High axial resolution (~5–10 µm)
-
Deep penetration for posterior and anterior imaging
-
Effective A-line rates of 250 kHz or higher
-
Robust performance even in small, embedded platforms
-
Clinical study competitive results available
Anterior Segment Imaging
Modular optical configurations allow adaptation for:
-
Angle visualization
-
Corneal and limbal imaging
-
Pre- and post-operative assessments
Retinal imaging development supported by NIH under SBIR Grant number 1R43EY036763-01A1
Unstitched, 64 frame average line scan taken on KineoLabs' internal prototype. All layers for clinical diagnosis are well resolved and competitive with state-of-the art point scanning systems.
INDUSTRIAL LINE-SCAN OCT APPLICATIONS
KineoLabs’ optically integrated platform extends to many applications in non-destructive, high-resolution industrial imaging, ideal for environments where size, reliability, and cost matter.
Use Cases Include:
-
Inline inspection of coatings, adhesives, and semiconductors
-
Layer thickness mapping in flexible electronics
-
Microfluidic cell monitoring
-
3D scanning of medical devices and microstructures
Line-field Architectures
Enables real-time high-speed 3D profiling over moving parts or conveyor lines.
Full-field OCT
Supports ultra-fast volume imaging with high spatial resolution, ideal for snapshot metrology or static part inspection.

Image of KineoLabs' OCT engine for OEM applications.
KEY DIFFERENTIATORS
Free-Space Optical Integration
No fiber. No external beam routing. Greater optical stability and design freedom.
Vertically Integrated Architecture
From tunable laser to scanning mechanics and optics—everything engineered as one system.
Compact and Customizable
Designed for embedded use in medical instruments, handheld devices, or industrial process lines.